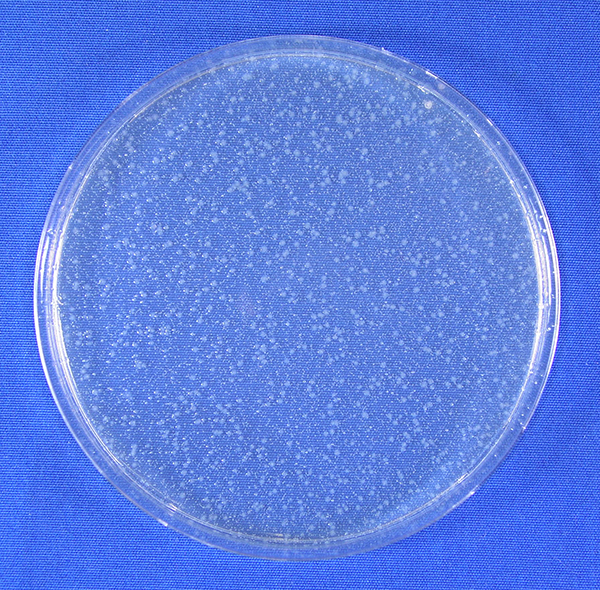

※エルーセラ島〈AE〉、グレートバリアリーフ〈AG〉、カントン島〈GC〉と奄美大島〈AA〉は好評につき完売いたしました。
| サイズ | 品番 | 希望小売価格 |
|---|---|---|
| 0.5L | MCS-A50J | 5,000円(税抜4,545円) |
地球の「色」を知り、地球の「色」で遊び、地球をもっと「好き」になってもらうため、宇宙から撮影した地球の色から作られた「海のクレヨン」(スカパーJSAT)
世界の海の衛星写真から選ばれた、名前はないが、理由はある色、12色。
そのうち5色をイメージした真空断熱ボトルが登場。
「真空断熱ボトル(保冷専用) MCS-A50J」の売り上げの一部は、海面上昇の危機に直面しているキリバス共和国に寄付し、自然災害基金として活用いただきます。
ボトル本体の正面には、海のクレヨンと同様、海の色を抽出した場所の座標(緯度・経度)を記しています。
背面には、コラボレーションの証として、「Satellite Crayon Project」と「TIGER」の
2つのロゴをデザイン。


MCS-A型は、ふた・せん・せんカバーに抗菌加工を施し、「スーパークリーンPlus」加工を採用した、タイガー魔法瓶独自の衛生仕様「BioGuard」シリーズです。

ふた・せん・せんカバーに抗菌加工を施し、いつでも衛生的にご使用いただけます。
MCS-A型には銀系(Ag)抗菌加工が施されています。

JIS Z 2801(ISO22196)基づいた抗菌試験結果写真
※本製品と同じ抗菌加工を施した当社MCT-K型の中せん樹脂での試験結果
SIAA マークは ISO22196 法により評価された結果に基づき、抗菌製品技術協議会ガイドラインで品質管理・情報公開された製品に表示されています。
SIAAマークは抗菌製品技術協議会が制定した抗菌のシンボルマークです。
①抗菌性(※1)、②安全性(※2)、③適切な表示(※3)と3つの基準を満たした製品にSIAAマークを表示することができます。

(※1)抗菌加工されていない製品の表面と比較し、細菌の増殖割合が百分の一以下であり、耐久性試験後も抗菌効果が確認されること。抗菌性は国際標準ISO22196に準じて行われた試験の結果にもとづいて判定されます。
(※2)SIAAが独自に決めた安全性基準を満たしていること。
(※3)抗菌剤の種類、加工部位を明示していること。
ボトルの内面には、なめらかで光沢のあるスーパークリーンPlusを施しました。汚れ・においがつきにくく、サビにも強いので塩分が含まれているスポーツドリンクを入れてもOK。
※使用後はすぐに水ですすぐなど、お手入れしてください。

ふたの開閉部は片手で開けやすい設計の「ループせん」を採用。ボタンを押すとロックが解除され、そのままループを指で支えてふたを開ける仕組みになっています。事務仕事中でも、アウトドアのときでもラクに水分補給がおこなえます。


当社独自のスピニング加工により軽量化を実現。
質量は約230g。

ステンレス真空2重構造により、高い保冷力を実現!飲みごろの温度を約6時間キープします。
取り外して隅々まで洗えるので、衛生的にお使いいただけます。

※動画のボトルはMCS-A50Jと同構造のせんを搭載したMCS-A050です。
真空断熱ボトル
| 品番 | MCS-A50J |
|---|---|
| 色柄 |
エルーセラ島<AE> 奄美大島<AA> グレートバリアリーフ<AG> カントン島<GC> 陰陽海<GO> |
| 容量 | 0.5L |
| 保冷効力(6時間) | 8℃以下 |
| サイズ 幅×奥行×高さ(約) |
6.6×7×24.5(cm) 本体のみ:6.6×7.0×20.5(cm) |
| 質量 (約) | 0.23kg |
| 口径(約) | 4(cm) |
| 生産国 | ベトナム |
※別のストアに移動します